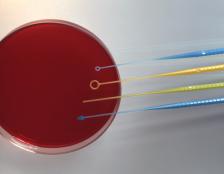

InocuLoopTM disposable inoculating loops have patented*, four-sided spreaders - like four streakers in one! Inoculate a petri dish with one, not multiple, disposable loops. InocuLoopTM is also ideal for making all your bacterial inoculation and quantitative procedures - such as sampling, serial dilutions and urine counts - faster and more efficient. Plus, the four surfaces end in an apex and can be used as a built-in picker for isolation colonies.
Choose 1 µl or 10 µl calibrated loops or a needle. Each case of InocuLoopsTM includes a free CaLoopbratorTM sizing gauge and ten extra loops from the same production lot for use as testers.
No more time-consuming Evans blue Dye calibraiton. The CaLoopbratorTM was partially based on the FDA drill bit method accepted by the United States Public Health Service. This unique device certifies that a loop is properly calibrated by allowing lab personnel to verify that a loop's diameter and thickness are within acceptable tolerances.
The green "GO" end of the gauge should pass through the loop, while the red "NO GO" end should not. In addition, the loop should pass sideways through the green "GO" slot but not through the red "NO GO" slot. If both "GO" tests are positive, the loop is in compliance.
Pre-sterilized InocuLoopsTM are gamma-irradiated and saves the time spent flaming metal loops. InocuLoopTM also eliminates the potential hazards associated with flame-sterilizing metal loops: spattering, cross-contamination and the chance of infection from aerosol pathogens.
Use InocuLoopTM when metal loops are unavailable or not suitable: such as anaerobic chambers, in the field and even in satellite testing.
A tamper-evident feature ensures sterility. Drawer boxes slide out so that users may remove loops by grasping the middle of the handles, not the ends. Plastic outer bags are resealable. For the most stringent requirements, InocuLoopTM is available individually-wrapped.
$171.14
|